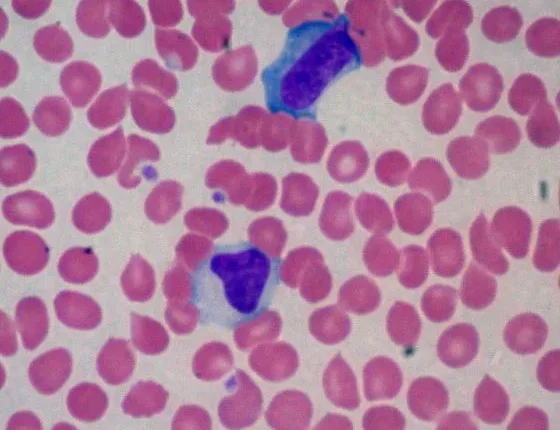

Λοιμώδης μονοπυρήνωση: Αίτια, συμπτώματα και θεραπεία
Η λοιμώδης μονοπυρήνωση είναι μία ιογενής νόσος που προκαλείται από τον ιό Epstein Barr (EBV) και ουσιαστικά είναι ένα είδος έρπητα. Είναι επίσης γνωστή και ως η «νόσος του φιλιού».
Ο λόγος είναι ότι συχνά εξαπλώνεται μέσω της άμεσης επαφής με το σάλιο. Η μονοπυρήνωση συμβαίνει σε όλο τον κόσμο και οι περισσότεροι άνθρωποι μολύνονται με τον συγκεκριμένο ιό κάποια στιγμή στη διάρκεια της ζωής τους.
Η λοιμώδης μονοπυρήνωση συμβαίνει συχνά στα παιδιά χωρίς να προκαλεί σοβαρά συμπτώματα, όμως οι έφηβοι και οι ενήλικες που προσβάλλονται από τον ιό μπορεί να βιώσουν μια εξουθενωτική διαδικασία μιας ασθένειας που μπορεί να διαρκέσει ακόμα και τέσσερις μήνες. Ενώ τα συμπτώματα της λοιμώδους μονοπυρήνωσης συνήθως υποχωρούν από μόνα τους μετά από έναν ή δύο μήνες, ο ιός μπορεί να παραμείνει αδρανής μέσα στο σώμα του ασθενούς για όλη του τη ζωή και περιστασιακά να καταστεί ενεργός και να εξαπλωθεί στους άλλους χωρίς να προκαλεί συμπτώματα στον ξενιστή.
Οι περισσότερες περιπτώσεις της λοιμώδους μονοπυρήνωσης συμβαίνουν σε εφήβους και ενήλικες μικρότερους των 35 ετών. Τα συμπτώματα περιλαμβάνουν πόνο στο λαιμό, πυρετό, κόπωση και διόγκωση των λεμφαδένων. Σε πιο σοβαρές λοιμώξεις μπορεί να συμβεί διόγκωση του ήπατος ή του σπλήνα. Σε σπάνιες περιπτώσεις η μόλυνση μπορεί να εξαπλωθεί στο κεντρικό νευρικό σύστημα ή την καρδιά και μπορεί επίσης να προκαλέσει ρήξη του σπλήνα. Οποιαδήποτε από αυτές τις καταστάσεις θεωρείται μια ιατρική έκτακτη ανάγκη που χρήζει άμεσης αντιμετώπισης. Ο θάνατος από λοιμώδη μονοπυρήνωση, ωστόσο, είναι αρκετά σπάνια περίπτωση.
Οι περισσότεροι ασθενείς με λοιμώδη μονοπυρήνωση ανακάμπτουν σε έναν έως τέσσερις μήνες. Τα συμπτώματα εμφανίζονται συνήθως τέσσερις έως έξι εβδομάδες μετά την έκθεση στον ιό. Ο ιός συνήθως μεταδίδεται μέσω της άμεσης επαφής με το σάλιο, έτσι ώστε εκείνοι που έχουν μολυνθεί θα πρέπει να αποφεύγουν τα φιλιά με τους άλλους όπως και την ανταλλαγή σκευών, ποτηριών ή οδοντόβουρτσας. Μόλις η νόσος συνεχίσει την πορεία της, τα συμπτώματα συνήθως υποχωρούν από μόνα τους και δεν επαναλαμβάνονται. Η λοιμώδης μονοπυρήνωση, ωστόσο, παραμένει στο σώμα και μπορεί να επανενεργοποιηθεί αργότερα στη ζωή, προκαλώντας την εξάπλωση της ασθένειας στους άλλους.
Η λοιμώδης μονοπυρήνωση συνήθως διαγιγνώσκεται μέσω ενός τεστ, του monospot, ένα είδος εξέτασης αίματος που ελέγχει αν υπάρχει στο σώμα ο ιός Epstein Barr. Η λοιμώδης μονοπυρήνωση είναι μια ιογενής νόσος που δεν είναι συνήθως θανατηφόρα και έτσι η επεξεργασία περιλαμβάνει συχνά ξεκούραση στο κρεβάτι και κατάλληλη «αυτοφροντίδα». Εκείνοι που έχουν μολυνθεί από τον ιό γενικά θα πρέπει να μένουν στο κρεβάτι και να αποφεύγουν την επαφή με τους άλλους στις σπουδές ή στην εργασία τους, μέχρις ότου ο ιός ολοκληρώσει την πορεία του. Παστίλιες για το λαιμό μπορεί να χρησιμοποιηθούν για να ανακουφιστεί ο πονόλαιμος που σχετίζεται με τη λοιμώδη μονοπυρήνωση όπως και φάρμακα που μπορούν να ανακουφίσουν τον πόνο του κεφαλιού και του σώματος. Εάν η διόγκωση στις αμυγδαλές, τους λεμφαδένες, τον λαιμό, το ήπαρ ή τον σπλήνα είναι σοβαρή, τότε μπορούν να χορηγηθούν κορτικοστεροειδή φάρμακα για την πρόληψη των απειλητικών επιπλοκών που μπορεί να συμβούν με την φλεγμονή.
